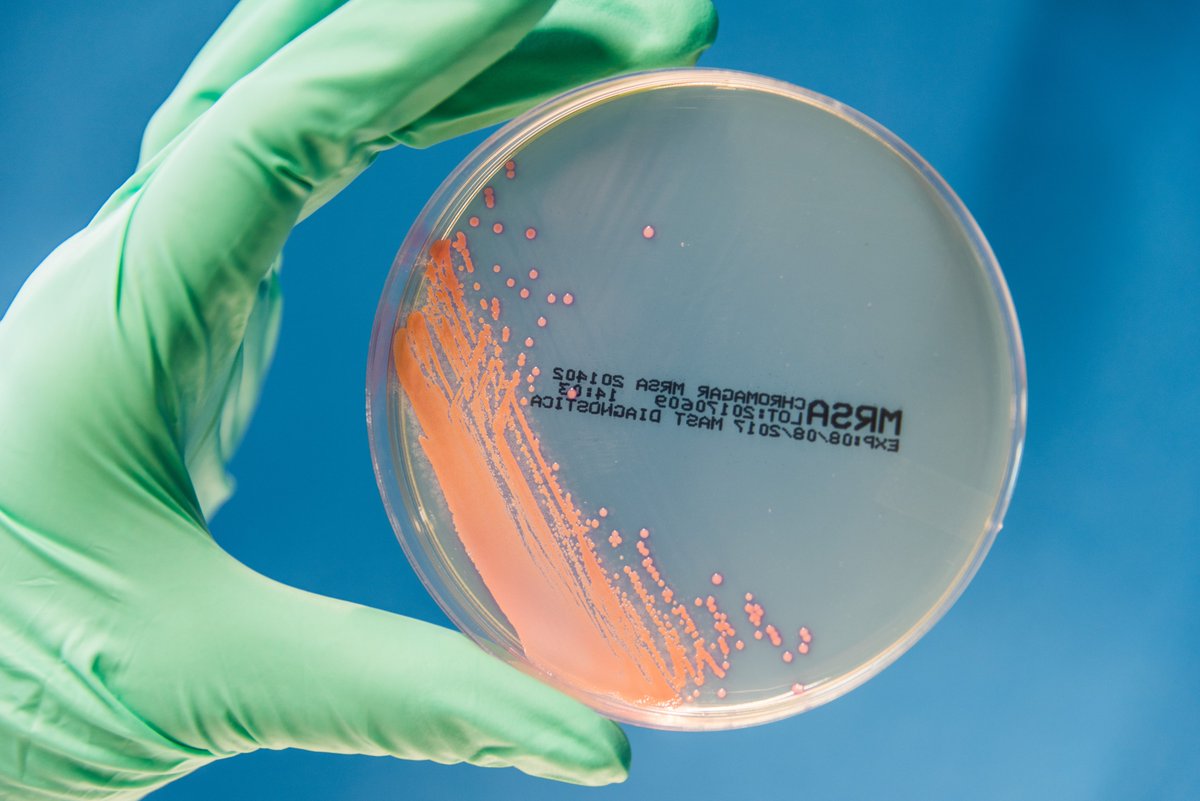
1/2
💊 Kriterien zur Einordnung eines Antibiotikums als Reserveantibiotikum und der zugrundeliegenden nicht abschließenden Liste multiresistenter bakterieller Krankheitserreger veröffentlicht. 
Zur aktualisierten Version von #RKI und <a href="/bfarm_de/">Bundesinstitut für Arzneimittel u. Medizinprodukte</a>:
➡️rki.de/DE/Content/Ins…

Bundesinstitut für Arzneimittel u. Medizinprodukte
@bfarm_de
Der Twitter-Account des Bundesinstituts für Arzneimittel und Medizinprodukte (BfArM) wurde stillgelegt. Sie finden uns bei LinkedIn: de.linkedin.com/com
ID: 803246507688394752
http://www.bfarm.de/impressum 28-11-2016 14:37:45
2,2K Tweet
9,9K Takipçi
538 Takip Edilen

The #HMA unites the national competent authorities - including the BfArM. The HMA works in and with EU Medicines Agency to make safe and effective #medicines quickly available to people in 🇪🇺 - in future also through the use of #AI: jahresbericht.bfarm.de/Jahresbericht/…


Halbzeit-Bericht zur European medicines agencies network strategy (EMANS). Darin halten die EU Medicines Agency und die Heads of Medicines Agencies (HMA) die bisherigen Strategie-Erfolge fest und bestätigen die Relevanz der bis 2025 gesetzten Fokusthemen.


Wir bieten eine Übersicht der aktuellen #CHMP Meeting Highlights der EU Medicines Agency. Darin u.a.: Empfehlungen zur #Zulassung neuer #Medikamente, Erweiterung therapeutischer #Indikationen, neue #EPAR und kürzlich gestartete Verfahren: bfarm.de/DE/Das-BfArM/E…


In einem Pilotprojekt von EU Medicines Agency + #HMA können Forschende der klinischen #Onkologie an der #Arzneimittelbewertung mitwirken. Ziel: Regulatorische Expertise + akademisch-klinisches Fachwissen verbinden. Das BfArM ist dabei Impulsgeber an vielen Stellen: jahresbericht.bfarm.de/Jahresbericht/…








1/2 💊 Kriterien zur Einordnung eines Antibiotikums als Reserveantibiotikum und der zugrundeliegenden nicht abschließenden Liste multiresistenter bakterieller Krankheitserreger veröffentlicht. Zur aktualisierten Version von #RKI und Bundesinstitut für Arzneimittel u. Medizinprodukte: ➡️rki.de/DE/Content/Ins…

Bei Kinderarzneimitteln sind wir insgesamt gut durch den Winter gekommen, bisher. Unsere Maßnahmen haben gewirkt. Ich danke den Herstellern, die mehr produziert haben, den hilfsbereiten Apothekern, den nicht hamsternden Eltern und unserem Bundesinstitut für Arzneimittel u. Medizinprodukte rnd.de/politik/kinder…















